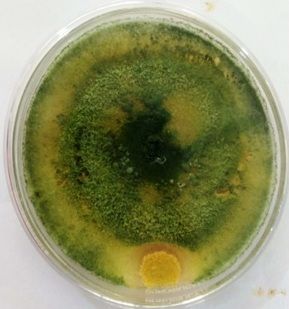

Trichoderma fungus
 Sep 06, 2019 • 4:06 AM UTC
Sep 06, 2019 • 4:06 AM UTC Unknown Location
Unknown Location 140x Magnification
140x Magnification Microorganisms
Microorganisms
Soumitra Banerjee
Learn about the author...
8posts
0comments
1locations

View in Media Gallery
By Vidya GA and Soumitra Banerjee
CIIRC-Jyothy Institute of Technology, Bangalore, Karnataka
The genus Tricoderma is one of the most abundant fungi that have been shown to be present in all climatic zones. As such, it can be found in virtually all soils or rotting wood given that they are found in the roots of plants. However, this fungi can also be found on various parts of plants including the leaves, seeds and grains. Tricoderma fungi can be found in many more habitats compared to other types of fungi. They are also more prevalent because they have developed the capacity to attack other fungi.
CIIRC-Jyothy Institute of Technology, Bangalore, Karnataka
The genus Tricoderma is one of the most abundant fungi that have been shown to be present in all climatic zones. As such, it can be found in virtually all soils or rotting wood given that they are found in the roots of plants. However, this fungi can also be found on various parts of plants including the leaves, seeds and grains. Tricoderma fungi can be found in many more habitats compared to other types of fungi. They are also more prevalent because they have developed the capacity to attack other fungi.
View in Media Gallery
Fig. Fungal growth found on a nutrient agar plate

View in Media Gallery
Fig. Filamentous Trichoderma fungus observed under foldscope
Sign in to commentNobody has commented yet... Share your thoughts with the author and start the discussion!

 0 Applause
0 Applause 0 Comments
0 Comments




